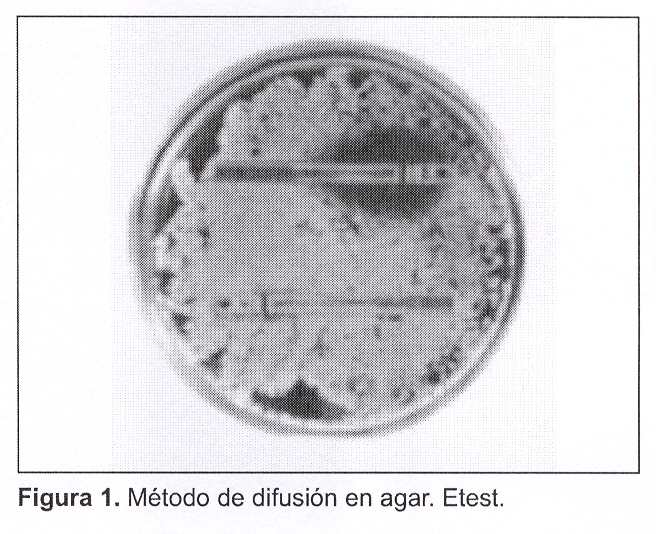

Serviços Personalizados
Journal
Artigo
Links relacionados
Compartilhar
Revista Médica del Uruguay
versão On-line ISSN 1688-0390
Rev. Méd. Urug. vol.22 no.2 Montevideo maio 2006
Evaluación del desempeño diagnóstico del medio de difusión en agar Etest® para el estudio de sensibilidad a los antifúngicos
Dres. Raquel Ballesté*, Zaida Arteta†, Ana Barloco‡, Cristina Mier§,
Nora Fernández¶, Nélida Mousqués††, Beatriz Xavier‡‡,
María José Cabrera††, Lic. Ana Combol§§, Dr. Elbio Gezuele¶¶
Departamento de Laboratorio Clínico, Hospital de Clínicas. Departamento de Parasitología y Micología, Instituto de Higiene. Facultad de Medicina. Universidad de la República. Uruguay
Resumen
El aumento de la incidencia de las micosis profundas ha generado la necesidad de desarrollar técnicas para el estudio de la susceptibilidad in vitro a los antifúngicos. El método de microdilución en caldo es el de referencia, sin embargo métodos alternativos surgen ante la necesidad de diagnóstico en el laboratorio clínico, siendo el Etest el método de difusión en agar más utilizado en nuestro medio.
En este trabajo se evaluó el desempeño diagnóstico del Etest en comparación con la técnica de referencia y se correlacionaron las concentraciones inhibitorias mínimas (CIMs) por ambos métodos.
Se estudiaron 80 cepas de Candida spp., procesándose por Etest y por microdilución en caldo (protocolo M27-A2 del National Committee for Clinical Laboratory Standards [NCCLS]).
Se probaron: anfotericina B (AB), itraconazol (ITZ) y fluconazol (FLZ). Se evaluó el desempeño diagnóstico del Etest con respecto a la metodología de referencia (EPIDAT, versión 2.0 para Windows) y se calculó la correlación mediante el coeficiente de Pearson.
El Etest presentó para el ITZ una especificidad y sensibilidad diagnóstica de 44% y 92%, respectiva-mente, valor predictivo positivo (VPP) de 60% y valor predictivo negativo (VPN) de 85%. Para el FLZ la especificidad y sensibilidad fue de 85% y 12,5%, respectivamente, VPP de 45% y VPN de 49%. Para AB el Etest no captó ninguna de las cepas resistentes. Los valores predictivos fueron calculados para detectar resistencia empleando los puntos de corte del National Committee for Clinical Laboratory Standards (NCCLS). Los coeficientes de correlación fueron los siguientes: r = - 0,02 (AB), r = - 0,03 (FLZ) y r = 0,4 (ITZ).
No se validó el método desde el punto de vista analítico por no existir correlación entre las CIMs obtenidas por el Etest y la técnica de referencia. De acuerdo con los resultados obtenidos, el desempeño diagnóstico de la técnica es poco confiable. Analizando el desempeño global del Etest a la luz de los conocimientos actuales no parece un método confiable para su uso en los laboratorios de análisis clínicos.
Palabras clave: RESISTENCIA A DROGAS ANTIFÚNGICAS.
AGAR – uso diagnóstico.
INMUNODIFUSIÓN – métodos.
TESTS DE SENSIBILIDAD MICROBIANA – métodos.
* Médico Parasitólogo. Médico Especialista en Laboratorio de Patología Clínica. Prof. Adj. Departamento de Parasitología y Micología. Prof. Adj. Departamento de Laboratorio Clínico del Hospital de Clínicas.
† Especialista en Medicina Interna. Asistente del Departamento de Parasitología y Micología. Asistente Clínica Médica A, Hospital de Clínicas.
‡ Especialista en Laboratorio Clínico. Asistente Departamento de Laboratorio Clínico del Hospital de Clínicas.
§ Especialista en Laboratorio Clínico. Prof. Adj. Departamento Laboratorio Clínico del Hospital de Clínicas.
¶ Médico Parasitólogo. Asistente Departamento de Laboratorio Clínico. Asistente del Departamento de Parasitología y Micología.
†† Médicos. Ayudantes del Departamento de Parasitología y Micología.
§§ Licenciada en Laboratorio Clínico.
¶¶ Médico Parasitólogo. Prof. Agdo. Departamento de Parasitología y Micología.
Correspondencia: Dra. Raquel Ballesté
Alfredo Navarro 3051. CP: 11600. Montevideo, Uruguay.
E-mail: micol@higiene.edu.uy - ballraq@adinet.com.uy
Recibido: 9/8/05.
Aceptado: 13/2/06.
Introducción
En las dos últimas décadas las nuevas tecnologías en terapias médicas y quirúrgicas han mejorado la calidad de vida y la sobrevida de un importante número de pacientes con neoplasias y otras enfermedades crónicas debilitantes. Sin embargo, como resultado de estas alternativas o debido a la enfermedad subyacente, o a la sumatoria de ambas, la consecuencia es la inmunodepresión(1-3).
Por otra parte, la epidemia del virus de la inmunodeficiencia humana (VIH) ha agregado una creciente población de individuos inmunodeprimidos, susceptibles a las infecciones nosocomiales causadas por hongos que antiguamente se consideraban de baja virulencia o no patógenos. Las infecciones fúngicas en estos pacientes son a menudo severas, rápidamente progresivas y de difícil diagnóstico y tratamiento(4,5).
La incidencia de las micosis invasoras ha aumentado significativamente en los últimos años, siendo las infecciones por Candida spp. responsables de 5% a 10% de las septicemias nosocomiales(6).
Durante períodos prolongados de internación en unidades de cuidados intensivos se genera mayor riesgo para contraer infecciones fúngicas oportunistas, entre ellas las candidiasis(6-12). En la década de 1980 las infecciones nosocomiales por levaduras aumentaron casi 500%, siendo las más frecuentes las producidas por levaduras del género Candida; la infección sistémica por ésta es causa de una morbimortalidad significativa.
Si bien Candida albicans (C. albicans) sigue siendo la causa más común de candidemia, aproximadamente 35% de las candidiasis sistémicas han sido reemplazadas por otras especies "no albicans", reportándose por tanto una emergencia de éstas(13-16). Datos reportados por el Instituto Nacional de Cáncer de Estados Unidos, revelan la importancia del fenómeno antes mencionado al evidenciar el aumento de la incidencia de las especies "no albicans" de 22% en 1992 a 52% en 1997(14).
Estas especies "no albicans" generan dificultades terapéuticas, emergiendo con ellas nuevos patrones de sensibilidad a los antifúngicos(17-19). A modo de ejemplo mencionamos: C. krusei, que presenta resistencia intrínseca al fluconazol; C. glabrata con un perfil de sensibilidad variable existiendo cepas con resistencia intrínseca y cepas que desarrollan resistencia secundaria al fluconazol; C. guillermondi, C. lusitaniae y C. parasilopsis con resistencia secundaria al fluconazol(20-24). Actualmente se han reportado cepas de C. glabrata y C. tropicalis resistentes a la anfotericina B(25,26).
En nuestro medio los primeros estudios realizados con las técnicas de referencia para estudio de susceptibilidad a los antifúngicos revelan la aparición de resistencia in vitro al fluconazol en cepas de Candida spp, aisladas de pacientes VIH positivos y de pacientes hospitalizados en unidades de cuidado intensivo(27-29).
El impulso de programas de investigación ha fructificado en la aparición de nuevas sustancias antifúngicas durante esta última década, que intentan ofrecer una nueva aproximación al tratamiento clásico de las micosis; sin embargo, es interesante mencionar que con el desarrollo de los triazoles (fluconazol e itraconazol), se inició el uso masivo de la terapia empírica e incluso de la profilaxis antifúngica(30,31). Estas prácticas terapéuticas están relacionadas con algunos de los cambios epidemiológicos antes mencionados, entre los que se destacan la aparición de cepas que han desarrollado resistencia secundaria a los antifúngicos y la sustitución de algunas especies sensibles por otras con resistencia intrínseca; frente a estos hechos se impone conocer el perfil de sensibilidad a los antifúngicos.
En los últimos años se han desarrollado técnicas para el estudio de la susceptibilidad in vitro a los antifúngicos, de las cuales el método de microdilución en caldo es considerado la técnica de referencia para dicho fin. El National Committee for Clinical Laboratory Standards (NCCLS) aprobó un primer estándar, para estudiar la sensibilidad a los antifúngicos en levaduras en el año 1999 (documento M27-A)(32), modificándolo posteriormente y aprobando en el año 2003 el estándar vigente (documento M27-A2)(33). Recientemente también se ha aprobado otro estándar para el estudio de sensibilidad en hongos miceliales (documento M38-A)(34).
Métodos alternativos surgen ante la necesidad de contar con técnicas que puedan ser utilizadas para diagnóstico diario en el laboratorio clínico(35); las técnicas de difusión en agar han sido ampliamente difundidas, siendo el Etest el más utilizado en nuestro medio. Este método no sólo permite catalogar a una cepa como sensible o resistente, sino que también suministra el valor de la concentración inhibitoria mínima (CIM). Esta virtud ha sido promovida por muchos autores; a ello se suma la fácil y rápida manipulación e interpretación de resultados, características que han hecho de esta técnica una de las más difundidas para el estudio de la sensibilidad a los antifúngicos(36). Sin embargo, numerosos trabajos han evaluado esta metodología tanto para levaduras como para hongos miceliales, mostrando resultados controvertidos en relación con la técnica de referencia(37-39).
El objetivo de este trabajo es evaluar el desempeño diagnóstico del Etest en comparación con la técnica de referencia, microdilución en caldo recomendada por el NCCLS para levaduras y correlacionar las CIMs obtenidas por ambos métodos.
Material y método
Cepas estudiadas
Se utilizaron 80 cepas del género Candida de la colección de levaduras guardadas en la Unidad de Parasitología y Micología de la Repartición Microbiología del Departamento de Laboratorio Clínico del Hospital de Clínicas "Dr. Manuel Quintela". Estas cepas fueron aisladas de pacientes a partir de diferentes muestras biológicas (hemocultivo, lavado bronquioalveolar, líquido peritoneal, muguet orofaríngeo, biopsias, entre otras).
Identificación de cepas
Las levaduras se identificaron a nivel de especie mediante metodología convencional, realizándose estudio micromorfológico de las colonias en agar Sabouraud, producción de tubos germinales, producción de clamidosporos, sensibilidad a la actidiona, actividad ureasa y asimilación de hidratos de carbono(40).
Las cepas fueron identificadas como: C. albicans (52), C. parapsilopsis (12), C. glabrata (5), C. tropicalis (5), C. krusei (3), C. lipolytica (1), C. famata (1), C. lusitaniae (1).
Estudio de sensibilidad a los antifúngicos
por método de referencia
Se realizó la técnica de microdilución en caldo para levaduras según el protocolo del NCCLS (documento M27-A2). Las concentraciones utilizadas del antifúngico a evaluar se observan en la tabla 1. Los puntos de corte considerados para catalogar a las cepas como sensibles (S), sensibles dosis dependiente (SDD) o resistentes (R) se especifican para cada antifúngico en la tabla 2, siendo los pautados en el documento M27-A2.
Estudio de sensibilidad a los antifúngicos por Etest (figura 1)
Se realizó la técnica de difusión en agar Etest siguiendo estrictamente las instrucciones del fabricante(36). Se optó por sembrar en Sabouraud a 2% considerando que éste es de uso habitual en los laboratorios que procesan muestras para estudio micológico. Los puntos de corte empleados fueron los puntos de corte recomendados por el NCCLS para la técnica de microdilución en caldo, tal como lo recomienda el fabricante.
Figura 1. Método de difusión en agar. Etest
Antifúngicos evaluados
Se estudió la sensibilidad al fluconazol (FLZ) y a la anfotericina B (AB) en la totalidad de las cepas, mientras que el itraconazol (ITZ) fue evaluado en 47 cepas de C. albicans, 12 C. parapsilopsis, 5 C. glabrata, 5 C. tropicalis, 3 C. krusei, 1 C. lipolytica, 1 C. famata, 1 C. lusitaniae.
Los estudios de sensibilidad fueron realizados con ambos métodos (método de referencia y Etest).
Análisis estadístico
Para la evaluación del desempeño diagnóstico del Etest se analizaron los parámetros de sensibilidad, especificidad y valores predictivos, los mismos se calcularon de la siguiente forma:
1) Sensibilidad (S) = verdaderos positivos / verdaderos positivos más falsos negativos.
2) Especificidad (E) = verdaderos negativos / verdaderos negativos más falsos positivos.
3) Valor predictivo de la prueba positiva (VPPP) = verdaderos positivos / verdaderos positivos más falsos positivos.
4) Valor predictivo de la prueba negativa (VPPN) = verdaderos negativos / verdaderos negativos más falsos negativos.
5) Eficacia diagnóstica = verdaderos positivos más verdaderos negativos / total de cepas estudiadas.
Los cinco parámetros de desempeño diagnóstico recién descriptos fueron calculados para detectar resistencia, considerando prueba positiva cuando cataloga a la cepa como resistente y prueba negativa cuando cataloga a la cepa como sensible, empleándose los puntos de corte recomendados por el NCCLS para ambas técnicas.
Para el cálculo del desempeño diagnóstico se incluyeron las cepas sensibles dosis dependiente dentro de las resistentes (por ambas técnicas), dado que este estadio es un evento previo al desarrollo de resistencia y podría determinar una mala respuesta clínica de acuerdo a la dosis con la que se realizara el tratamiento.
Los cálculos correspondientes al desempeño diagnóstico del método evaluado Etest con respecto a la microdilución en caldo (estándar de oro), fueron realizados con el programa EPIDAT (análisis epidemiológico para datos tabulados, versión 2.0 para Windows, Xunta de Galicia). Para determinar la correlación se calculó el coeficiente de correlación de Pearson (r), utilizándose el programa Excel de Microsoft.
Resultados
Evaluación del desempeño diagnóstico del Etest
En la tabla 3 se presentan los datos correspondientes de especificidad y sensibilidad diagnóstica para los diferentes antifúngicos evaluados.
La especificidad para el FLZ fue de 85% y la sensibilidad de 12,5%, con un VPPP de 45%, un VPPN de 49% y con una eficacia diagnóstica de 84%, calculados para un intervalo de confianza (IC) de 95%. Para el ITZ la especificidad y sensibilidad fue de 44% y 92%, respectivamente, con un VPPP de 60%, VPPN de 85% y una eficacia diagnóstica de 66%, IC de 95%.
Los valores empleados para el cálculo del desempeño diagnóstico del FLZ e ITZ se muestran en las tablas 4 y 5.
En relación con el desempeño diagnóstico del Etest para la anfotericina B, destacamos que sólo detectamos tres cepas resistentes por la técnica de referencia, al ser ésta una frecuencia relativa baja, la confiabilidad de los parámetros de desempeño diagnóstico disminuye al incrementar los intervalos de confianza de los mismos. Sin embargo, cabe destacar que el Etest no captó ninguna cepa resistente a la anfotericina B. La especificidad del método fue de 100% y el VPPN de 96,3%, haciendo la salvedad de que esta prevalencia alta de cepas sensibles y baja de cepas resistentes conllevan a que dichas estimaciones pierdan valor; los datos utilizados para dichos cálculos se muestran en la tabla 6.
Correlación de las CIMs obtenidas por Etest con la técnica
de referencia
Se calcularon los siguientes coeficientes de correlación, para el FLZ, r = - 0,03 (FLZ); para el ITZ, r = 0,4 y para la AB, r = - 0,02 (figuras 1, 2 y 3).
Discusión y conclusiones
Los resultados obtenidos revelan que el Etest tiene un desempeño diagnóstico pobre; la baja confiabilidad del método queda revelada claramente si observamos los bajos valores predictivos en general, así como también los bajos valores de sensibilidad para el FLZ (12,5%) y de especificidad para el ITZ (44%).
Si bien para el FLZ la especificidad diagnóstica fue razonablemente buena (FLZ = 85%), cabe destacar la baja sensibilidad diagnóstica que el método presentó para este antifúngico, siendo capaz de detectar sólo 12,5% de las cepas resistentes (verdaderos positivos), con un VPPP de 45%, es decir que cuando cataloga a las cepas como resistentes se equivoca 55 veces en 100.
El FLZ es un antifúngico que se emplea frecuentemente en tratamientos profilácticos de algunas micosis sistémicas y también para el tratamiento específico de dichas micosis; su bajo costo en comparación con otros antifúngicos de administración sistémica y sus escasos efectos colaterales son algunas de las características que hacen del FLZ el antifúngico de elección en el tratamiento de las candidiasis sistémicas.
De la conjunción de los hechos anteriormente mencionados rápidamente se puede comprender la importancia que tiene determinar si una cepa de Candida spp. es sensible o resistente a este fármaco. En el primer caso, sensible, el tratamiento con FLZ en principio es correcto, mientras que en la segunda situación, resistente, está indicado iniciar tratamiento con anfotericina B; dicho de otra forma, la emisión de un resultado falso negativo puede ser responsable de un desenlace fatal para el paciente, al catalogar como sensibles a cepas resistentes.
Para el ITZ, el Etest mostró un desempeño diagnóstico también pobre, con una sensibilidad diagnóstica buena (92%) pero con una especificidad baja (44%); también cabe destacar el bajo VPPP (60%), lo que implica que cuando el método cataloga a las cepas como resistentes se equivoca 40 veces en 100.
Determinar resistencia para al FLZ o al ITZ es vital a la hora de decidir una terapia antifúngica ya que el arsenal terapéutico con el que contamos en nuestro país es limitado, teniendo en cuenta que aún no están disponibles en el mercado antifúngicos de última generación como posaconazol, voriconazol o equinocandinas.
Desde el punto de vista analítico no es posible validar el método dado que no se encontró correlación entre las CIMs obtenidas con la técnica de difusión en agar Etest y la técnica de referencia, microdilución en caldo para levaduras del género Candida.
El desempeño global del Etest sugiere que aún no es confiable para su uso en los laboratorios de análisis clínicos, ya que la determinación de una cepa como sensible o resistente tiene implicancias clínicas al momento de decidir la conducta terapéutica, siendo de gran relevancia en pacientes críticos.
Se debe tener presente que un resultado falso positivo hará considerar a una cepa que es sensible como resistente, ello determinará la indicación de antifúngicos más potentes en situaciones en las que no es necesario; este uso inadecuado de los antifúngicos puede determinar con el paso del tiempo (al igual que ocurre con los antibacterianos) la aparición de cepas resistentes. Por el contrario, un resultado falso negativo tendrá implicancias directas sobre el paciente ya que será responsable del fracaso terapéutico al no catalogar a las cepas resistentes como tales.
Consideramos que en el caso de utilizarse el Etest como método para determinar la susceptibilidad a los antifúngicos en los laboratorios de análisis clínicos, el especialista del laboratorio encargado deberá tener presente la baja sensibilidad de la técnica para detectar cepas resistentes al FLZ, la baja especificidad que el método presenta para el ITZ, y el elevado porcentaje de error de que verdaderamente sean resistentes cuando lo detecta. En estos casos corresponde alertar al médico clínico y la conducta terapéutica se basará fundamentalmente en el contexto clínico del paciente y en la especie causal.
Finalmente, en relación con el estudio de susceptibilidad a los antifúngicos, destacamos que el desarrollo de métodos fiables para la detección de resistencia in vitro, junto con el aumento de micosis causadas por especies fúngicas que presentan resistencia intrínseca o secundaria a los antifúngicos, han hecho aumentar la importancia clínica de los estudios de sensibilidad a los antifúngicos; sin embargo, se hace hincapié en el uso de pruebas estandarizadas y recomendadas por diferentes comités formados para el estudio de este tema a los efectos de obtener una buena reproducibilidad intra e interlaboratorio. Es entonces en este contexto que estas pruebas permitirán implementar estrategias para el uso racionalizado de los antifúngicos, así como establecer pautas de manejo y control de las infecciones por levaduras.
Summary
The increase of the incidence of mycosis has led to develop new techniques to study in vitro antifungal susceptibility.
In this study, Agar Etest –the most used method of agar dilution in our country– was compared to the reference method –broth microdilution method– and the MICs for both techniques were correlated.
Eighty Candida spp. strains were studied using Etest and broth microdilution method (Protocol M27-A2 del National Committee for Clinical Laboratory Standards [NCCLS]).
Amphotericin B (AB), itraconazol (ITZ) and fluconazole (FLZ) were tested. Etest diagnostic performance was compared to the reference method (EPIDAT, version 2.0 for Windows); correlation was calculated using Pearson’s correlation coefficients.
Etest specificity and sensitivity for ITZ were 44% and 92% respectively, positive predictive value (VPP) was 60% and negative predictive value (VPN) 85%.
Specificity and sensitivity for FLZ were 85% and 12.5% respectively, VPP was 45% and VPN 49%. For AB, Etest did not detect resistant strains. Predictive values were calculated to detect resistance using NCCLS breakpoints. correlation coefficients were as follow: r = - 0,02 (AB), r = - 0,03 (FLZ) y r = 0,4 (ITZ).
The method was not validated since there was no correlation between MICs obtained by Etest and those obtained by the reference technique. According to the findings, diagnostic performance of the technique was not reliable. Global performance of Etest seems to be unreliable for clinical tests.
Résumé
L’augmentation de l’incidence des mycoses profondes signale la nécessité de développer des techniques pour l’étude de la susceptibilité in vitro aux anti-fungiques. La méthode de micro dilution est référentielle, pourtant, il existe des méthodes alternatives face au besoin de diagnostic dans le laboratoire clinique, parmi lesquelles le Agar Etest en est de diffusion en agar la plus utilisée ici.
Dans ce travail-ci, on a évalué l’action diagnostique du Etest en le comparant à la technique de référence et on mettant en corrélation les CMIs avec les deux méthodes.
On étudie 80 souches de Candida spp., par Etest et par micro dilution en (protocole M27-A2 du National Committee for Clinical Laboratory Standards [NCCLS].
On a essayé: amphotericine B (AB), itraconazole (ITZ) et fluconazole. On a évalué l’action diagnostique du Etest par rapport à la méthodologie de référence (EPIDAT, version 2.0 pour Windows) et on a calculé la corrélation au moyen du cœfficient de Pearson.
Le Etest a présenté pour le ITZ une spécificité et une sensibilité diagnostique de 44% et 92% chacune, valeur prédictive positive (VPP) de 60% et valeur prédictive négative (VPN) de 85%. Pour le FLZ la spécificité et la sensibilité a été de 85% et de 12,5% chacune, VPP de 45% et VPN de 49%. Pour AB, le Etest n’a capté aucune des souches résistantes. Les valeurs prédictives ont été calculées pour repérer la résistance en utilisant les points de coupe du NCCLS. Les coefficients de corrélation ont été: r= - 0.02 (AB). r= -0,03 (FLZ) et r=0,4 (ITZ).
On n’a pas validé la méthode du point de vue analytique n’existant pas de corrélation entre les CMIs obtenues par Etest et par la technique de référence. Selon les résultats obtenus, l’action diagnostique de la technique est peu fiable. En analysant l’action diagnostique du Etest d’après les connaissances actuelles, il ne semble pas une méthode fiable pour son utilisation aux laboratoires d’analyses cliniques.
Bibliografía
1. Wenzel RP, Pfaller MA. Candida species: emerging hospital bloodstream pathogens. Infect Control Hosp Epidemiol 1991, 12(9): 523-4.
2. Fox JL. Fungal infections rates are increasing. ASM 1993; 59: 515-8.
3. Salonen J, Nikoskelainen J. Lethal infections in patients with hematological malignancies. Eur J Haematol 1993; 51(2): 102-8.
4. Arteaga Hernández E, Capó de Paz V, Pérez Fernández-Terán ML. Micosis oportunistas invasivas en el SIDA: un estudio de 211 autopsias. Rev Iberoam Micol 1998; 15: 33-5.
5. Musial CE, Cockerill FR 3rd, Roberts GD. Fungal infections of the immunocompromised host: clinical and laboratory aspects. Clin Microbiol Rev 1988; 1(4): 349-64.
6. Diekema DJ, Messer SA, Brueggemann AB, Coffman SL, Doren GV, Herwaldt LA, et al. Epidemiology of candidemia: 3-year. Results from de emerging infections and epidemiology of Iowa organisms study. J Clin Microbiol 2002; 40(4): 1298-302.
7. Winston DJ, Emmanouilides C, Busuttil RW. Infections in liver transplant recipients. Clin Infect Dis 1995; 21(5): 1077-91.
8. Anaissie E, Bodey GP. Nosocomial fungal infections: old problems and new challenges. Infect Dis Clin North Am 1989; 3(4): 867-82.
9. Anaissie E, Bodey GP, Rinaldi MG. Emerging fungal pathogens. Eur J Clin Microbiol Infect Dis 1989; 8(4): 323-30.
10. Fraser VJ, Jones M, Dunkel J, Storfer S, Medoff G, Dunagan WC. Candidemia in a tertiary care hospital: epidemiology, risk factors, and predictors of mortality. Clin Infect Dis 1992; 15(3): 414-21.
11. Bodey GP. The emergence of fungi as major hospital pathogens. J Hosp Infect 1988; 11(Suppl A): 411-26.
12. Trick WE, Jarvis WR. Epidemiology of nosocomial fungal infection in the 1990s. Rev Iberoam Micol 1998; 15: 2-6.
13. Fisher-Hoch SP, Hutwagner L. Opportunistic candidiasis: an epidemic of the 1980s. Clin Infect Dis 1995; 21(4): 897-904.
14. Pfaller MA, Diekema DJ. Role of sentinel surveillance of candidemia: trends in species distribution and antifungal susceptibility. J Clin Microbiol 2002; 40(10): 3551-7.
15. Wingard JR. Importance of Candida species other than C. albicans as pathogens in oncology patients. Clin Infect Dis 1995; 20(1): 115-25.
16. Weems JJ, Chamberland ME, Ward J, Willy M, Padhye AA, Solomon SL. Candida parapsilosis fungemia associated with parenteral nutrition and contaminated blood pressure transducers. J Clin Microbiol 1987; 25(6): 1029-32.
17. Ghannoum MA, Rice LB. Antifungal agents: mode of action, mechanisms of resistance, and correlation of these mechanisms with bacterial resistance. Clin Microbiol Rev 1999; 12(4): 501-17.
18. White TC, Marr KA, Bowden RA. Clinical, cellular and molecular factors that contribute to antifungal drug resistance. Clin Microbiol Rev 1998; 11(2): 382-402.
19. Mahayni R, Vázquez JA, Zervos MJ. Nosocomial candidiasis: epidemiology and drug resistance. Infect Agents Dis 1995; 4(4): 248-53.
20. Lebowitz LD, Ashbee HR, Evans EG, Chong Y, Mallatova N, Zaidi M, et al. A two year global evaluation of the susceptibility of Candida species to fluconazole by disk diffusion. Diagn Microbiol Infect Dis 2001; 4(1-2): 27-33.
21. Durán MT, Velasco D, Canle D, Moure R, Villanueva R. Susceptibilidad antifúngica de aislados de Candida spp. de hemocultivos en un período de 5 años (1997-2001). Enferm Infecc Microbiol Clin 2003; 21(9): 488-92.
22. Pfaller MA, Jones RN, Messer SA, Edmond MB, Wenzel RP. National surveillance of nosocomial blood stream infection due to species of Candida other than Candida albicans: frequency of occurrence and antifungal susceptibility in the SCOPE program, SCOPE Participant Group. Surveillance and control of pathogens of epidemiologic. Diagn Microbiol Infect Dis 1998; 30(2): 121-9.
23. Pfaller MA, Jones RN, Doern GV, Sader HS, Hollis RJ, Messer SA. International surveillance of bloodstreams infections due to Candida species: frequency of occurrence and antifungal susceptibilities of isolates collected in 1997 in the United States, Canada, and South America for SENTRY Program. J Clin Microbiol 1998; 36(7): 1886-9.
24. Nguyen MH, Peacock JE Jr, Morris AJ, Tanner DC, Nguyen ML, Snydman DR, et al. The changing face of candidemia: emergence of non–Candida albicans species and antifungal resistance. Am J Med 1996; 100(6): 617-23.
25. Powderly WC, Kobayashi GS, Herzig GP, Medoff G. Amphotericin B-resistant yeast infection in severely immunocompromised patients. Am J Med 1988; 84(5): 826-32.
26. Nguyen MH, Clancy CJ, Yu VL, Yu YC, Morris AJ, Snydman DR, et al. Do in vitro susceptibility data predict the microbiologic response to amphotericin B? Results of a prospective study of patients with Candida fungemia. J Infect Dis 1998; 177(2): 425-30.
27. Ballesté R, Arteta Z, Mousqués N, Xavier B, Cabrera MJ, González M, et al. Antifungal susceptibility in Candida strains isolated of oral cavity of positive HIV patients. World STI/AIDS Congress, 8. Punta del Este, Uruguay December 2-5, 2003.
28. Ballesté R, Arteta Z, Mousqués N, Xavier B, Cabrera MJ, Gezuele E. Opportunistic Mycosis on HIV-AIDS Patients. World STI/AIDS Congress, 8. Punta del Este, Uruguay. December 2-5, 2003.
29. Rieppi G, Ballesté R, López L, Arteta Z. Candidemias en Centro de Terapia Intensiva. Tratamiento, seguimiento, pronóstico y susceptbilidad a los antifúngicos. Congreso Uruguayo de Medicina Interna, 9. Montevideo, Uruguay. 2003.
30. Steinbach WJ, Perfect JR. Newer antifungal therapy for emerging fungal pathogens. Int J Infect Dis 2003; 7(1): 5-20.
31. Sobel JD, Vázquez J. Candidiasis in the intensive care unit. Seminars in respiratory and critical care medicine 2003; 24(1): 99-111.
32. National Commitee for Clinical Laboratory Standards. Reference method for broth dilution antifungal susceptibility testing of yeast. Appoved Standard. Document M27-A. Pensilvania: National Commitee for Clinical Laboratory Standards, 1997.
33. National Commitee for Clinical Laboratory Standards. Reference method for broth dilution antifungal susceptibility of yeast. Approved Standarard. Document M27-A2. Pensilvania: National Commitee for Clinical Laboratory Standards, 2002.
34. Pfaller M, Viishnu CH, Espinel-Ingroff A. Reference method for broth dilution antifungal susceptibility testing of filamentous fungi. NCCLS document M38-A. Approved Standard. Pensilvania: Nationa Committee for Laboratory Standars, 2000.
35. Vandenbossche I, Vaneechoutte M, Vandevenne M, De Baere T, Verschraegen G. Susceptibility testing of fluconazol by the NCCLS broth macrodilution method, E-Test, and disk diffusion for application in the routine laboratory. J Clin Microbiol 2002; 40(3): 918-21.
36. AB BIODISK. Etest Technical guide 4b: Antifungal susceptibility testing of yeasts. Piscataway, New Jersey: AB BIODISK, 1994.
37. Colombo AL, Barchiesi F, McGough DA, Fothergill AW, Rinaldi MG. Evaluation of the E test system versus a microtitre broth method for antifungal susceptibility testing of yeasts against fluconazole and itraconazole. J Antimicrob Chemother 1995; 36(1): 93-100.
38. Dannaoui E, Colin S, Pichot J, Piens MA. Evaluation of the Etest for fluconazole susceptibility testing of Candida albicans isolated from oropharyngeal candidiasis. Eur J Clin Microbiol Infect Dis 1997; 16(3): 228-32.
39. Clancy C, Nguyen MH. Correlation between in vitro susceptibility determined by Etest and response to therapy with amphotericin B: results from a multicenter prospective study of candidemia. Antimicrob Agents Chemother 1999; 43(5): 1289-90.
40. Kwon-Chung K, JE. B. Medical Mycology. Philadelphia: Lea & Febiger, 1992.